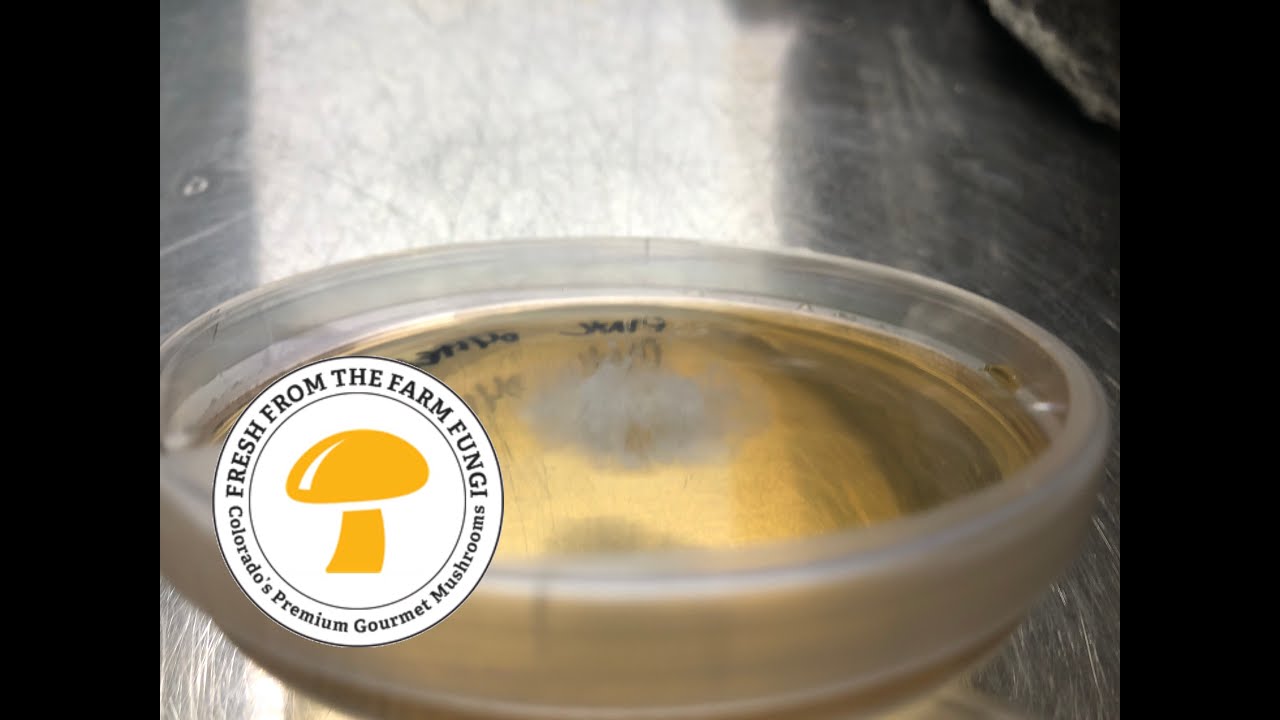
Breeding Project day 6 Transferring Isolate Colonies

Breeding project 3 week update: Multispore liquid cultures and clamp connections
Автор: Fresh from the Farm Fungi
Загружено: 2020-03-09
Просмотров: 8986
Описание:
This video is about our gourmet mushroom breeding project. In this 3 week update, we cover multispore liquid cultures, mycelium clamp connections and some exciting cross breeding experiments - for more info visit http://freshfromthefarmfungi.com and to purhcase our live cultures visit https://www.etsy.com/shop/freshfungi MUSHLOVE
Gary's Recommended Mushroom Equipment and Growing Gear: https://www.amazon.com/shop/influence...
Повторяем попытку...

Доступные форматы для скачивания:
Скачать видео
-
Информация по загрузке: